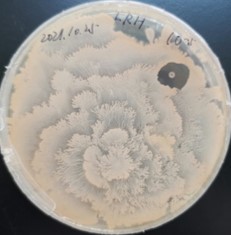

为生动展示微生物世界的魅力,提升校内同学对微生物等学科的学习兴趣,普及微生物的学科基础知识,献礼中国共产党成立100周年、厦门大学建校100周年、厦门大学化学学科创建100周年暨化工系创办30周年,厦门大学化学化工学院生物化工研究所于2021年12月20日-12月27日,举办了第四届微生物培养皿艺术设计大赛。

(第四届微生物培养皿艺术设计大赛签名墙)
本次大赛由《微生物学实验》授课教师王远鹏、王海涛主持,参赛选手为生物工程专业学生以及对微生物实验感兴趣的化学化工学院的本科生及研究生。参赛分为专业组与非专业组。专业组为2019级生物工程本科生,非专业组为兴趣报名参赛选手。两组均设置专业赛道即平板作画,其中专业组另设艺术设计赛道之显微镜照片图像处理。
与以往不同,本次比赛平板作画赛道的作画方式做了一定方法的改进,采用两种作画方式,同学的操作变得更加简便,图片选择范围更广。其一为棉签描摹法:使用灭菌细棉签蘸取菌液,在培养基上轻轻描摹图案。生长出形状后可以用灭菌牙签修正边缘。该方法的优点在于可写字或绘制线条复杂的图案,且可在同一块平板上使用多种颜色的菌,缺点是描摹时力度过大可能会戳破培养基,不适合画边缘尖锐的图案(线条宽度约1.5mm)。其二为锡纸雕刻法:在锡纸上雕刻出图案并消毒,覆盖在均匀涂布过菌液的培养基上,紫外照射30分钟后揭去锡纸。该方法的优点是可以提前设计好图案,且图案可以打印,可以生长出边缘清晰的图块,缺点是只能选用一种颜色的菌,锡纸柔软,需特别注意操作力度。


(第四届微生物培养皿艺术设计大赛颁奖典礼)
比赛过程中,参赛选手或发挥自己的奇思妙想,绘画自己喜欢的事物,一幅幅精美的作品纷纷跃然于培养皿之上。经过一番激烈角逐,大赛评委共评选出一等奖6名,二等奖14名,三等奖16名(获奖名单详见附件1)。
部分获奖作品展示如下:
专业组一等奖


张鸿钰《中国版图》 郑雅匀《纪念袁隆平》
非专业组一等奖


张雨豪《红船映雪》 王根源《嘉庚先生与百年厦大》
专业组二等奖


高雅文《福到啦》 张子钰《篆刻:南方之强》


孙云峰《百年校庆吉祥物小厦》 杨文楷《iGEM》
非专业组二等奖



王皓天《凤凰花又开》 张姗姗《虎年吉祥》 陈东威《祝祖国繁荣昌盛》


徐更新《红船》 王琪琪《献礼建党百年》

武顺妹《百年征程,扬帆起航》
艺术设计赛一等奖作品

原图 成品
李荣豪《冬日梦幻》

原图 成品
杨文楷《银河》

原图 成品
梁若曦《荒山枯草》

原图 成品
谢林海《蝶恋花》

原图 成品
陈宇欣《女娲补天》

原图1 原图2 原图3 原图4

张鸿钰《厦大100周年与显微镜下的细胞》
本届“微生物培养皿艺术设计大赛”的成功举办离不开大赛组委会的精心策划统筹以及《微生物实验》课程助教的集思广益还有广大同学们的积极参与。比赛有助于加深同学们对微生物学习的兴趣,强化同学们对专业的认识理解,帮助同学们提升设计实验能力、解决问题能力以及工程应用能力,引导同学们思考职业生涯规划。未来,化学工程与生物工程系将持续创新实验教学模式,吸引更多微生物领域高素质人才,不断深化教育教学改革,弘扬嘉庚精神,培养优秀人才,为国家富强、人民幸福和中华文化海外传播做出积极贡献。
附件1 获奖名单-第四届微生物培养皿艺术设计大赛.pdf
文/胥丽纯
图/《微生物实验》课程王远鹏、王海涛、全体助教以及参赛选手